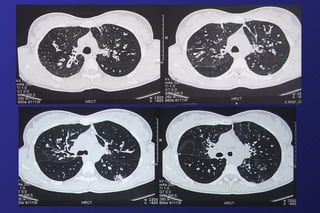

Le bronchiectasie sono dilatazioni irreversibili delle vie aeree, spesso causate da infezioni respiratorie ricorrenti e patologie come la fibrosi cistica. La diagnosi precoce è facilitata da tecniche di imaging avanzate e i sintomi includono tosse persistente e accumulo di muco. Le bronchiectasie possono complicare condizioni come i trapianti e richiedere una gestione terapeutica mirata.